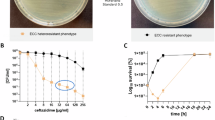

Abstract
Species within the Enterobacter cloacae complex (ECC) include globally important nosocomial pathogens. A three-year study of ECC in Germany identified Enterobacter xiangfangensis as the most common species (65.5%) detected, a result replicated by examining a global pool of 3246 isolates. Antibiotic resistance profiling revealed widespread resistance and heteroresistance to the antibiotic colistin and detected the mobile colistin resistance (mcr)−9 gene in 19.2% of all isolates. We show that resistance and heteroresistance properties depend on the chromosomal arnBCADTEF gene cassette whose products catalyze transfer of L-Ara4N to lipid A. Using comparative genomics, mutational analysis, and quantitative lipid A profiling we demonstrate that intrinsic lipid A modification levels are genospecies-dependent and governed by allelic variations in phoPQ and mgrB, that encode a two-component sensor-activator system and specific inhibitor peptide. By generating phoPQ chimeras and combining them with mgrB alleles, we show that interactions at the pH-sensing interface of the sensory histidine kinase phoQ dictate arnBCADTEF expression levels. To minimize therapeutic failures, we developed an assay that accurately detects colistin resistance levels for any ECC isolate.
Similar content being viewed by others
Introduction
Members of the order Enterobacterales are a frequent source of morbidity and mortality associated with bloodstream, respiratory tract, and urinary tract infection in healthcare institutions worldwide1,2. Among the Enterobacterales, Enterobacter are opportunistic nosocomial pathogens listed among the top five species causing bloodstream infections (BSI)3,4,5, and are in WHO’s priority list for which new antimicrobials are urgently needed6. Enterobacter are also present in environmental habitats such as soil and water and exhibit considerable phenotypic and genomic diversity7. As a result of taxonomical complexity, pathogenic species are commonly grouped within the Enterobacter cloacae complex (ECC)8. Infections with Enterobacter species are difficult to treat as they often exhibit resistance to penicillin, quinolones, and third-generation cephalosporins9. While carbapenems are among the most attractive therapeutic options, Enterobacter species have emerged as the third most common hosts for carbapenemases worldwide forcing the use of colistin as a “last-resort” antibiotic for the treatment10,11,12.
Colistin and other cationic peptides are membrane-active agents that target the lipopolysaccharide (LPS) component of the bacterial outer membrane (OM)13. Colistin is often considered a last-line therapeutic option for treating Enterobacter infections, but the prevalence of resistance among Enterobacter species is uncertain. Minimum inhibitory concentration (MIC) determinations show high variability depending on the test methods used14. The WHO Global Antimicrobial Resistance Surveillance System (GLASS) reports Enterobacter species as being naturally susceptible to colistin15,16. Other studies indicate that resistance towards colistin is either rare or can comprise up to 17% of all Enterobacter species17,18. A recent systematic study of Enterobacterales found that ~20% of Enterobacter isolates were colistin resistant, as compared to <2% isolates for E. coli and Klebsiella17.
Enterobacter isolates frequently exhibit heteroresistance towards colistin making accurate resistance testing difficult19,20 leading to a high risk of treatment failures, particularly with those isolates that have previously been classified as susceptible19,21. Previous studies have implicated the two-component systems (TCSs) PhoPQ/PmrAB that regulate expression of the arnBCADTEF gene cassette22,23, the PhoPQ inhibitor- MgrB and enhancer- Ecr peptides24, the inner membrane protein DedA24, and AcrAB-TolC efflux pump25 with colistin heteroresistance in different species of Enterobacter. Recent studies indicate that the TCS PmrAB is not involved in heteroresistance towards colistin in E. cloacae20,22. In addition, taxonomic conflicts in ECC have further complicated efforts to consistently identify genetic features underlying heteroresistance at the species level. Membership based on a hsp60 gene classification scheme first provided clues for distinct cluster-dependent heteroresistance levels and sensitive populations within ECC20,26. However, heteroresistance frequencies varied greatly within specific clusters suggesting mutations in additional genes or allelic differences underly these findings.
In this study, we performed a genome-based taxonomic study on clinical isolates of Enterobacter obtained over a 3-year period from six university hospitals at different locations in Germany. Our data suggest temporal and geographic predominance of the species E. xiangfangensis, a finding that was replicated by examining whole genome sequences of 3246 isolates from clinical sources worldwide. In contrast to previous reports, we find that colistin resistance and heteroresistance in the genus Enterobacter are widespread, involving over 80% of all known species. As the problem of heteroresistance and its impact on unexplained treatment failures of clinical infections are of great concern, we applied phylogenomics, antimicrobial susceptibility testing, lipid A profiling together with isogenic deletion mutation and complementation analysis to reveal mechanisms that characterize colistin heteroresistance in Enterobacter.
Results
Enterobacter xiangfangensis lineage-1 as the most common Enterobacter in clinical samples
Based on MALDI-TOF and VITEK data, the majority (86.0%) of the isolates were identified as E. cloacae, 8.4% as unknown Enterobacter species, 3.0% as E. asburiae, and 1.2% as E. cloacae complex, a single isolate each as E. cancerogenus and E. ludwigii. To study taxonomic assignments in greater details, we sequenced and studied one-third of isolates from each center (n = 165, 96 from BSI and 69 from body sites) (Supplementary Data 1b).
We calculated the “overall genome relatedness index” (OGRI) of isolates by comparing them to type strains of 23 valid Enterobacter species as of June 2022 (Supplementary Data 5). OGRI-based genome analysis identified 12 Enterobacter species from 165 isolates. Of these, a total of 108 (65.5%) were identified as E. xiangfangensis, 23 (13.9%) as E. ludwigii, and 9 isolates each as either (5.4%) E. kobei or E. roggenkampii (Supplementary Table 1). The species E. bugandensis, E. cloacae, E. asburiae, E. chengduensis, E. mori, E. wuhouensis, E. cancerogenus, and E. vonholyi were observed only sporadically (≤5 isolates each) (Fig. 1a). In total, 67 (69.8%) of 96 isolates from BSI were E. xiangfangensis, followed by E. ludwigii (12.5%) (Supplementary Table 2, Supplementary Data 1).
a A total of 165 Enterobacter isolates were studied. Genome-based species classification showed E. xiangfangensis as the most frequent species at all centers. Values in parentheses denote the % of total Enterobacter (n = 165) isolates. The outline map of Germany is obtained from https://vemaps.com. b Phylogenomic distribution of the Enterobacter isolates obtained between 2011 and 2018 from six different study centers. Whole-genome sequence-based study of 165 Enterobacter isolates revealed 65.4% of isolates to be E. xiangfangensis. Bayesian Analysis of Population Structure (BAPS) in concordance with the multi-phylogenomic approach (concatenate core genes (shown here), core- and whole-genome) clustered E. xiangfangensis isolates into four lineages. A majority (60% of E. xiangfangensis isolates) belonged to Lineage-1, which harbor arnBCADTEF gene cassette associated with colistin heteroresistance. Importantly, 9 E. xiangfangensis and 4 other Enterobacter species isolates carried the recently identified mobile colistin resistance gene mcr-9. The hsp60 types correlated well to the phylogenomic lineages. The lineages were supported by bootstrap values (100). The distribution data for the isolates are provided in the Source data file.
Core genome-based phylogenomics analysis together with Bayesian Analysis of Population Structure (BAPS) distributed E. xiangfangensis isolates into four major lineages, which we assign as Lineages (L)-1 to -4 (Fig. 1b). Isolates clustered consistently in four lineages irrespective of phylogenomic approaches used (see Supplementary Fig. 1). A total of 64 of 108 E. xiangfangensis observed (59.2%) were members of L-1 isolates, while L-2, L-3, and L-4 were represented by 26, 11, and 7 isolates, respectively.
We used the OGRI-based approach to clarify the taxonomy of the publicly available genomes based on high-quality assemblies of Enterobacter from 67 countries. A total of 2233 from 3246 (68.7%) isolates deposited as ECC or Enterobacter species were identified as E. xiangfangensis (Supplementary Data 2). Country-wise analysis (comprising 35 countries for which more than five genome sequences were available) indicated that E. xiangfangensis, particularly isolates of L-1, was the predominant species detected in 29 countries and comprised between 61 to 100% of all Enterobacter isolates reported therein (Supplementary Table 3).
MLST typing further sub-classified the members of each species (see Fig. 1b and Supplementary Data 1b). The most abundant “E. cloacae” MLST types were ST-50 and ST-190, both associated with the species E. xiangfangensis, L-1. Further analysis of individual MLST clones showed differences of <70 nucleotides while the pan genome differed by between 24 to 385 genes (particularly of ST-50, ST-190, ST-108, and ST-175) indicating recent spread from a common ancestor (see Supplementary Data 7). These closely related isolates of specific MLST type were obtained from different centers and at different times suggesting broad distribution and persistence of commonly occurring clones throughout Germany.
High occurrence of mcr-9 gene in E. xiangfangensis
All of the 108 E. xiangfangensis isolates encoded resistance genes for ß-lactams (cephalosporins) and phenicols class of antibiotics. A further 92% and 91% of E. xiangfangensis isolates carried genes encoding quinolone and fosfomycin resistance, respectively. Aminoglycoside, sulfonamide, and trimethoprim resistance-conferring genes were present in <25% isolates, while tetracycline, rifamycin, carbapenem, streptothricin, and bleomycin were rare (<10%). Interestingly, 9 (8.3%) E. xiangfangensis, 2 E. ludwigii and a single isolate of E. kobei and E. chengduensis each, which carried the mobile colistin resistance (mcr)-9 gene, were identified (Fig. 1b). Presently, an average of 2.5% (0.1–5.1%) of clinical isolates obtained from various infections are reported to carry mcr alleles27 (Supplementary Table 4). This contrasts with the relatively high (8.3%) number of clinical E. xiangfangensis with the mcr-9 gene in this study. Analysis of worldwide isolates revealed a total of 24.8% of E. xiangfangensis isolates harbor the mcr-9 gene, while the presence of other mcr alleles (mcr-1, 3, 4, and 10) was rare (up to 1.4%) (Supplementary Data 2 and Supplementary Fig. 2).
We explored the genetic environment by sequencing ten mcr-9 carrying isolates to completion. For seven E. xiangfangensis isolates, the mcr-9 gene was located on an IncHI2 plasmid (pMLST type ST1), while one isolate (RBL-18-0082-1) carried a truncated version of the mcr-9 on the chromosome. For two of the seven E. xiangfangensis isolates (RPF-17-0249-1, L-1; RBL-18-0082-1, L-2) that carried mcr-9 on plasmid, there was an internal mutation leading to frameshifts in their respective reading frames (Supplementary Fig. 3). In E. ludwigii (RPB-16-0320-1) the mcr-9 gene was chromosomally located. Regardless of its location, the mcr-9 was surrounded by IS903-like IS elements described by Kieffer et al.28 in the upstream region, while IS26-like, IS102B, or IS1R IS elements were present downstream of the gene. The wbuC gene was present in seven isolates, whereas the qseB/qseC/ATPase/int structure was detected in only one isolate. Altogether, these results indicate heterogeneity of mcr-9-encoding elements.
Studies using the BMD assay showed that colistin resistance in these Enterobacter isolates remain unaffected, regardless of whether the mcr-9 gene was present.
Colistin resistance and heteroresistance are associated with the presence of arnBCADTEF
Comparative genomics of colistin-susceptible versus -resistant isolates showed that resistance patterns associated strongly with the presence of the arnBCADTEF gene cassette (arn) (Table 1). Isolates of E. wuhouensis, E. xiangfangensis lineages L-2, L-3, and L-4, and ST133 isolates of E. xiangfangensis L-1 that lacked arn showed colistin MICLB ≤ 4 mg/L (or MICEUCAST ≤ 2 mg/L). The remaining isolates of E. xiangfangensis L-1 and all other species with arn exhibited MICLB > 4 mg/L (or MICEUCAST > 2 mg/L) (Table 1 and Supplementary Data 1b). Notably, for the arn encoding isolates, the MICLB for colistin varied between 4 and ≥512 mg/L in a species-dependent manner. Isolates of E. xiangfangensis (L-1), E. asburiae, E. ludwigii, E. bugandensis, E. cancerogenus, E. chengduensis, E. cloacae, E. kobei, and E. roggenkampii had MICLB varying between 2 to ≥512 mg/L. A single isolate of E. vonholyi, that encoded arn, was observed to be sensitive (due to truncated regulator component phoQ; detailed below).
In repeated testing for colistin susceptibility using the BMD method for the same isolate, twofold to fourfold changes in the MICLB with the “skip wells” phenomenon were observed indicating heteroresistance towards colistin29. Using the PAP assay, we calculated heteroresistance frequency (HRF) i.e., the percentage of cells grown on LB agar plate containing colistin as compared to the inoculum used for all the species encountered. Only those isolates that carry an intact arn/phoPQ system exhibited heteroresistance, while isolates lacking this system or carrying truncated versions, showed neither the “skip well” phenomenon nor exhibited heteroresistance in PAP assay (Table 1). This data indicated, as with colistin resistance, that an intact arn/phoPQ system is required also for colistin heteroresistance.
We examined for the presence of arn in Enterobacter in additional species that were not detected in this study. Screening of genomes of Enterobacter species retrieved from public databases revealed that, of the 23 Enterobacter species known today (July 2022), 19 carry the arn gene cassette (Supplementary Data 2). The location of this cassette is always found between the same core genes on the chromosome (Supplementary Fig. 4). In those species lacking arn, there is a clean excision of this gene cassette leaving the same flanking genes intact. In summary, all the isolates of E. xiangfangensis L-2, L-3, and L-4, E. hormaechei, E. wuhouensis, and a single isolate (i.e. type strain) of E. timonensis lack arn. These isolates lacking arn form a unified clade (Fig. 1b and Supplementary Fig. 2). As Enterobacter species carried arn at an identical chromosomal location and were members of a single phylogenomic clade indicated that arn was lost during the evolution of Enterobacter.
Heteroresistance levels correlate with the intrinsic level of lipid A L-Ara4N-modification
To define the nature of structural modifications associated with colistin resistance we extracted lipid A from various isolates of E. xiangfangensis grown either in the presence or absence of colistin (2 mg/L) (Fig. 2a and Supplementary Data 4). Only isolates encoding arn (most L-1 isolates) could modify their lipid A with L-Ara4N. Such isolates grown in the absence of colistin showed lipid A molecules with only a single L-Ara4N substitution either at the 4’- (R1) or 1’- (R2) phosphate. Growth of these isolates in presence of colistin resulted in a significant overall increase of L-Ara4N modifications, and in part with double substitution. Strains that lacked the arn gene cassette did not show any modifications of lipid A. The general structure of Enterobacter lipid A is shown in Fig. 2b, all lipid A species observed in our MS analyses are listed in Supplementary Data 4. Representative MS spectra for E. xiangfangensis isolates are shown in Supplementary Fig. 5 and such spectra are the source of reported ion intensities used for lipid A ratio calculation (Supplementary Data 4). Of note, in isolates carrying the mcr-9 gene, no phosphoethanolamine (PEtN) modification was observed, indicating that mcr-9 is either non-functional or not induced under the growth conditions used. The same MS-based lipid A analysis was performed for representative strains of the remaining 11 Enterobacter species grown in colistin-free media. We detected varying levels of L-Ara4N modification of lipid A in individual isolates representing different species (Fig. 2c).
a Heat map summarizing the MS-based analysis of L-Ara4N-modification levels of lipid A in selected E. xiangfangensis strains. Corresponding, representative mass spectra are shown in Supplementary Fig. 5, further details are specified in Supplementary Data 4. b General chemical structure of Enterobacter lipid A. c Heat map summarizing the MS-based analysis of L-Ara4N-modification levels of lipid A in 11 other Enterobacter species observed in this study. d Various Enterobacter isolates grown at identical conditions (LB broth, O.D.600 0.8–1.0, without colistin) were analyzed for L-Ara4N-modification of lipid A ((see panels a and c), Supplementary Data 4) and for their correlation with % of heteroresistant cells (on a plate containing 8 and 32 mg/L of colistin), and % of cells survived after colistin treatment (64 mg/L for 15 min). The % of heteroresistance CFUs at 8 and 32 mg/L was positively associated with L-Ara4N-modification levels of lipid A (Pearson’s correlation coefficient, r = 0.88 and 0.73, respectively). This data suggested colistin heteroresistance to be directly associated with such levels. Given that only a fraction of isogenic growing population survives on plates containing 8 and 32 mg/L of colistin, we determine the % of cells that can survive after colistin treatment (64 mg/L for 15 min) by Live/DeadTM staining assay. This assay showed a positive association (r = 0.86) between % of cells survived and L-Ara4N-modified lipid A. This data indicated that only a certain number of cells from isogenic growing population carried modified lipid A and can survive when exposed to colistin, resulting in the heteroresistance phenomenon. This data show that cells with L-Ara4N-modified lipid A form the founder population of the colistin heteroresistance (also see Supplementary Table 5). Source data are provided as a Source data file.
We wondered if the levels of lipid A modification seen in cultures grown in the absence of colistin reflected the fraction of heteroresistant bacteria observed by the PAP assay. In addition, we compared HRFs to the levels of lipid A modified with L-Ara4N for representative strains of all the species studied when grown under the same conditions. We found a very strong positive correlation between the proportions of L-Ara4N-modified lipid A and their HRF (Pearson correlation coefficient: 0.88 and 0.73 for 8 and 32 mg/L colistin, respectively) indicating heteroresistance essentially reflects the level of intrinsically modified lipid A when isolates are grown in media without colistin (Fig. 2d and Supplementary Table 5).
We next determined if L-Ara4N-modification levels of lipid A represented minor sub-populations within isogenic growing population. To differentiate between intact and damaged membranes from isogenic growing population, we used LIVE/DEADTM staining following exposure of bacteria to a high concentration (64 mg/L) of colistin for 15 min and observed cell populations using fluorescence microscopy (Supplementary Fig. 6). Analysis of arn carrying Enterobacter species revealed sub-populations of cells with intact membranes, inferring their survival during colistin treatment. The percentage of cells survived showed positive correlation (r = 0.86) with the levels of modified lipid A. Exposure of bacteria for longer time (up to 4 hours) at high colistin concentration (64 mg/L) did not result in additional killing and the percentage of cells that survived were comparable to that of 15 min. The high correlation of lipid A L-Ara4N-substitution levels to HRF and proportions of live cells under identical growth conditions suggests that a genetic basis underlies the presence of sub-populations observed for the different species.
Allelic differences in phoQ and mgrB determine colistin resistance and heteroresistance
In Enterobacterales, expression of arn has been shown to be dependent on pmrAB, phoPQ, and the PhoPQ-feedback inhibitor mgrB22,30. To determine the role of genetic components involved in the colistin resistance or heteroresistance, we created and studied isogenic mutants of arn (i.e., arnBCADTEF gene cassette), pmrAB, phoPQ, and mgrB in a representative E. xiangfangensis L-1 isolate RBK-17-0394-1 (henceforth called Ex394).
While the parental isolate Ex394 exhibited a MICLB of 2–32 mg/L towards colistin, the Δarn mutant had a MICLB of only 0.5 mg/L (Fig. 3). Reintroduction of the arn on the low copy pBBR1-MCS2 plasmid reinstated the MICLB to 8-16 mg/L, demonstrating an absolute requirement of this gene cassette for colistin resistance activity. Deletion of phoPQ also lowered colistin resistance (2 mg/L), while the MICLB exhibited by the ΔpmrAB mutant was comparable to that of the parental strain at 4–16 mg/L. For the ΔmgrB mutant, encoding the negative regulator of PhoPQ, high MICLB levels of 128–>512 mg/L were observed. Genetic complementation by reintroduction of the respective gene deleted in these mutants restored MICLB levels to that seen with the parental Ex394 strain.
Comparative genomics of colistin-resistant and -sensitive isolates revealed that arnBCADTEF is necessary for colistin heteroresistance. In Enterobacterales, arnBCADTEF expression is controlled by the TCS PhoPQ, while the activity of the PhoPQ pathway is inhibited by the small transmembrane protein MgrB. Deletion mutants were created in E. xiangfangensis L-1 isolate RBK-17-0394-1 (WT) and studied for the MICLB and HRF (number of cells recovered on LB agar plate containing 8 or 32 mg/L of colistin/number of cells inoculated). MICLB was measured by BMD while HRF was calculated by PAP test. Analysis of mutants showed the phoPQ/arnBCADTEF axis is absolutely required for the colistin heteroresistance, while MgrB acts as a negative regulator of arnBCADTEF resulting in colistin susceptibility. As reported previously by Kang et al.22 for E. cloacae, PmrAB did not contribute to colistin resistance in E. xiangfangensis. Source data are provided as a Source data file. The MIC data is provided in the Source data file.
We extended this data by examining the levels of L-Ara4N substitution of lipid A. Lipid A preparations from the Δarn and ΔphoPQ mutants were totally devoid of L-Ara4N modifications, while the ΔpmrAB and the parental strain Ex394 showed similar levels of lipid A substitutions under both growth conditions (Supplementary Data 4). The ΔmgrB mutant exhibited high levels of L-Ara4N substitution even when grown in the absence of colistin. In the LIVE/DEADTM staining assay the ΔmgrB mutant showed higher numbers of viable bacteria as compared to WT, while Δarn and ΔphoPQ had relatively lower numbers of surviving bacteria following colistin treatment (Supplementary Fig. 6 and 7).
To understand variations in the MICLB and HRFs of different Enterobacter species we examined phoPQ/mgrB loci for allelic differences. Analysis of nucleotide sequences of gene and their promoter regions showed high conservation for the mgrB locus (Supplementary Data 6). Significant differences were noted within the coding regions of PhoP and PhoQ, while the respective phoPQ promoter region was highly conserved. Species-wise differences were observed in the amino acid sequences of PhoPQ suggesting allelic changes could lead to differences in resistance and heteroresistance levels.
As the various Enterobacter species that harbor different alleles of PhoPQ have a wide range of MICLB and HRF, we introduced the phoPQ alleles from E. bugandensis RBG-17-0246-1 (Eb246) and E. roggenkampii RPB-17-0516-2 (Er516), that each exhibit MICLB of between 64 and >128 mg/L, into the Ex394ΔphoPQ mutant (Fig. 4). Complementation with the heterologous phoPQ246 or phoPQ516 genes in ΔphoPQ394 mutant resulted in recombinants that exhibited MICLB of 64–128 mg/L, respectively. The HRF increased to 42.33 ± 4.78% and 10.83 ± 1.43% on 8 and 32 mg/L colistin with phoPQ246 complementation. For the strain complemented with phoPQ516, HRFs were 7.13 ± 2.75% and 1.05 ± 0.19% on 8 and 32 mg/L colistin, respectively (Supplementary Table 6).
The hybrid complement mutants were created by combining phoP and phoQ genes either of E. xiangfangensis RBK-17-0394-1 (Ex), E. bugandensis RBG-17-0246-1 (Eb), and E. roggenkampii RPB-17-0516-2 (Er). Plasmids harboring phoP-phoQ hybrids were transferred to Ex394ΔphoPQ. Complementation of the phoQ from the isolates exhibiting higher colistin heteroresistance i.e., Eb and Er to the ΔphoPQ mutant of E. xiangfangensis RBK-17-0394-1 resulted in the colistin resistance equivalent to respective parent strains. Complementation of the ΔmgrB mutant of E. xiangfangensis RBK-17-0394-1 with the mgrB from Eb (which has an identical amino acid sequence as of Er) resulted in slightly lesser inhibition due to changes in the binding energy (detailed in Supplementary Fig. 9). The MIC data is provided in the Source Data file.
These results were also examined by analysis of transcript levels of the arnBCADTEF operon. Compared to complementation with phoPQ394, the transcript levels of arnBCADTEF increased by 20.84-fold when complemented with phoPQ246 and 2.75-fold with the phoPQ516 allele following transfer into the Ex394ΔphoPQ mutant (Supplementary Fig. 8). Mass spectrometric analysis of L-Ara4N modifications of lipid A indicated that it was highest in ΔphoPQ strain complemented with phoPQ246 followed by phoPQ516 and then phoPQ394 (Supplementary Table 5). This was further validated using the LIVE/DEAD assay (Supplementary Fig. 6 and 7). We observed higher ratios of viable bacteria for the phoPQ246 complemented strain, followed by phoPQ516 and the phoPQ394 complemented strains.
To differentiate between the individual role of alleles of phoP and phoQ, we created hybrid versions of phoPQ by generating chimeric combinations of phoP and phoQ from each of Ex394, Eb246, and Er516, and transferring them to the ΔphoPQ394 mutant (Fig. 4). Among the different combinations of phoP and phoQ alleles, those that carried phoQ246 had the highest MICLB and HRF levels, followed by phoQ516, and was lowest with phoQ394. Unlike the results obtained with the respective phoQ alleles, no significant difference in MICLB was observed with phoP alleles deriving from the 246/516/394 strains. These data implicate the PhoQ sensor component of the PhoPQ two-component system as a major determinant in the activation of arnBCADTEF transcription and expression.
We next addressed the contribution of the mgrB gene from Eb246/Er516, whose sequences are identical, through the introduction of the complementing plasmids into the ΔmgrB394 mutant. Recombinants complemented with the mgrB246/516 allele exhibited an elevated MICLB of 64 mg/L, with a HRF value of 2.10 ± 1.13% and 0.96 ± 0.66% at 8 and 32 mg/L of colistin, respectively. In contrast, complementation with the homologous mgrB394 allele reduced colistin MICLB values to 4-16 mg/L and expressed a HRF value of 0.34 ± 0.24% and 0.22 ± 0.09% at 8 and 32 mg/L of colistin, respectively (Fig. 4).
An assay for unambiguous determination of colistin resistance in Enterobacter spp.
For the species Salmonella typhimurium and Escherichia coli, the TCS PhoPQ senses acidic pH as an environmental signal and regulates components required for the adaptation and survival of bacteria under these conditions. We reasoned that screening of Enterobacter isolates grown in culture media at a low pH would overcome MgrB-mediated suppression of PhoQ and lead to constitutive expression of the arn gene cassette, thereby promoting colistin resistance. We examined all the isolates in this study for colistin resistance by growing cultures at pH 7 and pH 5. Those Enterobacter isolates that carry intact copies of genes corresponding to the phoPQ/mgrB/arn axis, showed 4 to 16-fold higher MICLB when tested at pH 5 and generally exceeded 256 mg/L (Fig. 5a and Supplementary Data 1). The PAP test carried out by growing Ex394 on colistin LB agar plate adjusted for pH 5 showed a higher HRF (35.41 ± 7.78% and 5.33 ± 0.29%, on 8 and 32 mg/L colistin, respectively) than that at pH 7 (0.745 ± 0.27% and 0.505 ± 0.15%) (Fig. 5b). Mass spectrometric analysis of Ex394 grown at pH 5 and pH 7 validated these results and showed higher L-Ara4N-modification levels of lipid A in isolates grown at pH 5 as compared to pH 7 (Supplementary Data 4). Thus, at pH 5 suppression of PhoQ by MgrB is overcome, and results in the activation of the PhoPQ-dependent regulon that includes the arnBCADTEF gene cassette.
a MICLB and b HRF. The MICLB and HRF were studied by BMD assay and PAP test for isolates of 12 species observed in this study. The red and blue boxes (in a) depict MICLB at pH 5 and 7, respectively. Enterobacter species exhibiting lower HRFs are shown also in the inset (in b). The MICs and HRFs for each individual isolate are provided in the Source data file. Keys for box and whisker plot: The black center line denotes the median value (50th percentile), while the red or blue box contains the 25th to 75th percentiles of dataset. The black whiskers mark the inter-quartile range (1.5× IQR) and outlier points are shown individually.
Discussion
Taxonomic uncertainty associated with identifying members of the ECC together with problems relating to routine microbiology susceptibility testing for colistin resistance underestimate both the true prevalence of these bacteria in causing infections and mask the extent of how widespread this resistance is in these bacteria. ECC isolates, along with E. coli and Klebsiella pneumoniae, often harbor carbapenemases, forcing the therapeutic use of colistin worldwide. An expansion of genomic lineages of colistin-resistant Enterobacter species would be potentially concerning as relatively few antibiotic combinations remain as further treatment options. Adding to these concerns, problems associated with heteroresistance pose a serious threat because infections with Enterobacter are notoriously persistent and difficult to treat. The development of simple, reliable diagnostic methods that recognize resistance and heteroresistance is therefore urgently needed.
Genome-based taxonomy provided consistent and robust topologies allowing the identification of E. xiangfangensis as the predominant clinical species both in Germany as well as worldwide. To improve the utility of this taxonomic scheme and further encourage studies on historical isolates, we carried out a backward compatibility analysis to the previously developed based on hsp60 gene analysis31. This enabled retrospective analysis of Enterobacter isolates from several studies published previously, e.g. Hoffman et al. (comprising isolates from both the USA and European countries)31, Paauw et al. (The Netherlands)7, Morand et al. (France)32, Garinet et al. (France)32, Moradigaravand et al. (UK)33, Akbari et al. (Iran)34, Peirano et al. (carbapenemase-resistant worldwide isolates)12, Wang et al. and Zhou et al. (China)35,36. From these retrospective studies we found a predominance of hsp60 clusters -III, -VI, and particularly -VIII, which are essentially identical to lineage-1 isolates of E. xiangfangensis determined here, suggesting that this is the most commonly occurring species among clinical isolates worldwide, going back over a period of at least two decades (Supplementary Data 2).
Although heteroresistance towards colistin in Enterobacter species was first reported in 200737, the often inconsistent MIC values and complications in interpreting data from the “skipped well” phenomenon have made determinations on the overall prevalence of colistin resistance difficult20,22,38,39. Thus, according to current WHO classifications, Enterobacter species are listed as being generally susceptible to colistin15,16. The emergence of transferable colistin resistance through plasmids, and in particular the extremely high occurrence of mcr-9 (~20%) in Enterobacter spp. had added further urgency in understanding the true levels of colistin resistance in ECC40.
To correlate lipid A profiles, heteroresistance frequency and data from microscopic studies, we determined MICs using identical growth conditions i.e., using LB broth. When compared to MIC levels obtained with standard EUCAST protocols, the MICLB values were either similar or two-fold higher (Supplementary Data 1b). As with the EUCAST approach the “skipped well” phenomenon was also observed during MICLB determinations. Levels of colistin resistance depend on the extent of modified lipid A molecules with substitutions that reduce the electronegative potential of lipopolysaccharide (LPS). From this study we conclude that L-Ara4N modification of lipid A is solely responsible for colistin resistance (and heteroresistance) in ECC, as we observed PEtN-based substitutions only in up to 1.2% (Supplementary Data 4), even in those isolates that carry mcr-9 but lack the arnBCADTEF gene cassette. Based on the taxonomic scheme developed and from functional characterization of lipid A modifications in representative isolates we conclude that 20 of 23 Enterobacter species are inherently colistin resistant. Interestingly, for the remaining species, where most isolates are members of the sublineages L-2, L-3, and L-4 of E. xiangfangensis, we show clonal loss of the arnBCADTEF gene cassette associated with a clean excision event. As these represent a significant subset of Enterobacter isolates found at different sites in this study, the implication of this observation, i.e., if it is adaptive or provides growth advantages needs to be explored. Alternatively, the ubiquitous presence of this gene cassette in several members of the order Enterobacterales including Enterobacter, E. coli, and K. pneumoniae suggest that, in these lineages, it could be rapidly reacquired from close relatives.
The species-specific heteroresistance observed in this study and previous hsp60 cluster-based studies20,26 showed that the degree of heteroresistance differs across Enterobacter species (Table 1). In Enterobacterales, resistance towards colistin is complex and multifactorial requiring genes encoding structural components as well as those involved in LPS transport and its modification, together with associated regulatory genes41. Quantitative lipid A analysis of isogenic mutants and complementation analysis demonstrated that colistin resistance requires the presence of an intact arn/phoPQ/mgrB axis. Strikingly, when complemented, recombinants also exhibited skip-well phenomenon in MICLB testing assays, indicating that these genes also control inherent heteroresistance capacity29,42.
A major finding in this study using heterologous complementation assays was that those allelic differences in the two component phoPQ sensor-activator system from different species govern levels of heteroresistance. Thus, isolates that exhibit high heteroresistance levels could confer this property, when the respective phoPQ alleles were transferred to an isogenic mutant strain from an isolate exhibiting low heteroresistance propensity. Quantitative transcriptional analysis demonstrated overexpression of the arnBCADTEF operon in the isogenic mutant depending on the phoPQ allele introduced. This increased transcription also corresponded to an increase in the level of L-Ara4N modification of lipid A in the complemented recombinant strains. By creating chimeric phoPQ allelic pairs, we demonstrated that qualitative changes in the periplasmic membrane interacting domain of the sensor PhoQ control expression levels of the arnBCADTEF gene cassette. Using a similar approach, we determined that the level of colistin resistance is also determined by allelic differences in its inhibitor peptide MgrB.
Our observations are supported by molecular modeling studies. The PhoQ-MgrB interactions predicted that introduction of the altered mgrB246/516 allele from a highly resistant strain would significantly alter the MICLB level of the moderately colistin resistant strain Ex394 because of the higher activation energy required for its interaction with the phoPQ394 allele (Supplementary Fig. 9). As predicted, the introduction of mgrB246/516 into Ex394ΔmgrB enhanced its MICLB suggesting less efficient repression of the endogenous PhoQ sensor component by this variant. Detailed analysis of PhoQ-MgrB indicated that the α/β-core of PhoQ (aa 43–180) interacts with the C-terminal aa residues 34–47 of MgrB. Our data extends data from a recent study showing the importance of the interaction of the C-terminal periplasmic region of MgrB with PhoQ.
Previous studies showed that two pathways leading to acquired colistin resistance may exist in various Enterobacter and Klebsiella species, one involving the PmrAB, and another associated with PhoPQ41. Our data are consistent with the role of the TCS PhoPQ and its inhibitor MgrB, but do not support a role for the PmrAB pathway. This is consistent with data presented by Kang et al.22 for E. cloacae, who did not find any role of pmrAB in colistin resistance. It was previously shown that colistin-resistant sub-populations of an isolate of E. cloacae increased in peritoneally infected mice even in the absence of co-treatment with colistin, and that this property was associated with the phagocytic capacity of resident macrophages38. This selective increase in the frequencies of these sub-populations is attributed to components of the innate immune response including cationic antimicrobial peptides, reactive oxygen species generated by NADPH oxidases and lysozyme38.
We show here that these sub-populations are already present during growth in broth cultures without antibiotics suggesting that a fraction of an isogenic population of bacteria experience microenvironment changes that results in metabolic heterogeneity43,44,45. These includes changes in osmolarity, oxygen tension, ion flux, pH, as well as periplasmic transmembrane proteins that are all monitored by periplasmic histidine kinase sensors, such as PhoQ. In the case of S. typhimurium and other related bacteria, activation of the PhoQ sensor by antimicrobial peptides and acidic pH are separate and additive46,47. Our studies suggest a pre-eminent role for environmental pH as a signal since cells pre-grown at acidic pH exhibited higher MICLB and HRFs, which is further elevated when cells are pre-grown at acidic pH and in presence of colistin. Under conditions of growth at physiological pH, heteroresistance is a function of the qualitative differences in protein interactions that govern PhoPQ-MgrB interactions in sub-populations sensing microenvironmental pH differences. Flooding the growth environment with protons would constitutively activate PhoPQ and as expected, prior exposure of bacterial cells in the absence of colistin at pH 5 induced high levels of lipid A L-Ara4N-modification and exhibited elevated levels of HRF as compared to those at pH 7 (Fig. 6). Both acidic pH and antimicrobial peptides are likely to be encountered in the host viz., during the passage of the gastrointestinal tract or within the phagolysosomes of macrophages following phagocytosis and sensing of these signals would activate transitory gene expression programs to enable bacterial resilience in responding to the varying environments encountered during infection.
The PhoQ component (of the two component system PhoPQ) senses environmental conditions (for e.g., low pH and cationic antimicrobial peptide (CAMP)), which results in a change in its conformation leading to phosphorylation of PhoP. Phosphorylated PhoP binds to the promoter of many genes, including arnBCADTEF. Expression of arnBCADTEF results in the addition of L-Ara4N to lipid A, which changes the overall charge of the outer membrane causing colistin resistance. a Under normal growth conditions (LB, pH 7) PhoQ of the overall growing population is strongly inhibited by MgrB30. As a result of microenvironmental changes experienced during growth, a portion of the isogenic growing population has activated PhoQ with concomitant expression of the arnBCADTEF loci that result in L-Ara4N-modified lipid A. Only these cells survive when exposed to colistin (HRF + ). Overall, levels of modified lipid A are low. b As a result of low pH (pH 5) during growth conditions, MgrB is prevented from interacting with PhoQ, resulting in higher expression of the arnBCADTEF cassette and subsequent L-Ara4N-modified lipid A in a higher number of cells. Quantitative lipid A analysis confirms these observations and these populations exhibit increased survival (HRF++). c In the presence of subinhibitory concentrations of a cationic antimicrobial peptide such as colistin (2 mg/L), the antibiotic penetrates the outer membrane and is sensed by PhoQ strongly weakening interactions with MgrB and thereby releasing expression of arnBCADTEF. This results in L-Ara4N-modified lipid A in a higher number of bacteria. When exposed to colistin, these populations show relatively high survival levels (HRF+++). d As a result of low pH (pH 5) and antimicrobial peptide colistin during growth, PhoQ experiences a cumulative effect, and thus MgrB inhibition is strongly prevented, resulting in heightened expression of arnBCADTEF cassette and subsequent arabinose modified lipid A in a higher number of cells. These populations exhibit increased survival (HRF++++). (Core sugars and fatty acids of the LPS are only drawn symbolically and do not reflect exact structures).
Our data establish a comprehensive overview of the major Enterobacter species that are associated with BSI worldwide. The generation of species-specific profiles—using MALDI-TOF, based on the taxonomic scheme described here—is highly desirable and would provide for rapid and robust species designations in clinical, microbiological laboratories. We show that members of the species Enterobacter are inherently colistin-resistant due to L-Ara4N modification of lipid A. Finally, we identify environmental fluctuations in pH as the major determinant of heteroresistance levels via sensing by the PhoPQ two-component regulatory system and its inhibitory MgrB peptide and exploit this information to develop a simple, robust assay that unambiguously monitors colistin resistance in Enterobacter spp. and would avoid treatment failures in healthcare institutions worldwide. The elements driving clonal heteroresistance are also highly conserved in the order Enterobacterales, such as in the species Klebsiella, thereby opening the path for generic tests to accurately determine colistin resistance across a broad spectrum of clinically relevant bacteria.
Methods
Ethics
The study was approved by the ethics committee of the coordinating site (Cologne) and all sampling sites (Ethical committee approval, coordinating site Cologne: EA4/018/14).
Isolates and antibiotic resistance profiles
Bacterial strains used in this study are listed in Supplementary Data 1. Cultures were grown in Luria-Bertani (LB) broth (per liter composition: 10 g tryptone, 5 g yeast extract, 10 g NaCl, pH 7) (BD Difco™ Dehydrated Culture Media).
A total of 480 clinical Enterobacter isolates (bloodstream, n = 408 and colonization n = 72) were obtained between 2016 and 2018 from six university hospital centers (Berlin, Lübeck, Cologne, Gießen, Tübingen, and Freiburg) within a surveillance project targeting multidrug-resistant bacterial organisms (R-Net: https://www.dzif.de/en/node/915) (Supplementary Data 1a). Bloodstream infection isolates were obtained through routine diagnostics following clinical indication. Colonization isolates were obtained from newly admitted patients (<48 h hospitalization) on selective agar plates for resistant isolates. Of 480 isolates, 141 were randomly selected (~one-third from each site) and supplemented with 24 historical isolates circulating in Germany (between year 2011-2015, random selection). A total of 165 isolates (bloodstream infections (n = 96) and rectal swabs (n = 69)) were sequenced and studied (Supplementary Data 1b). These isolates were identified as Enterobacter spp. using MALDI-TOF (VITEK MS) or the VITEK2® GN ID card (bioMérieux, France). Antibiotic resistance phenotypes were determined using the VITEK2® system.
Colistin resistance was determined by calculating minimum inhibitory concentrations (MIC) using the broth microdilution (BMD) using two methods (i)- following CLSI-EUCAST Polymyxin Breakpoints Working Group recommendations48 and (ii) using LB medium with higher inoculum. In brief, 10 µL from a 30% glycerol stock (in LB broth) was revived in 2 mL LB broth (in pre-sterilized 14 mL PP tube, Greiner Bio-One, Cat. No. 187261) by incubation at 37 °C for 18 h at 180 rpm. The culture was diluted 1:100 in fresh 5 mL Mueller Hinton Broth 2 cation adjusted (MHB2) broth (Merck Millipore, Cat. No. 90922), in 14 mL PP tube and incubated at 37 °C at 180 rpm till an O.D.600 of 0.08–0.1 (equivalent to 0.5 McFarland standard) or if needed, adjusted by addition of further MHB2 broth49. For BMD, a 100 µL inoculum was added to 100 µL of MHB2 pre-supplemented with colistin sulfate to obtain a range of 512, 256, 128, 64, 32, 16, 8, 4, 2, 1, 0.5, and 0 mg/L in 96-well plate using a pipetting robot (Assist Plus, Integra). Plates were incubated without shaking at 37 °C for 16–20 h, and readings were taken by a Tecan 96-well plate reader (Infinite M200 Pro, Tecan Group Ltd. Maennedorf, Switzerland) at 600 nm. E. coli ATCC 25922 was used as a control for MICs. To correlate the results from other experiments (microscopy, PAP test and lipid A levels), we also determined the MICs in LB broth (MICLB). In all, 10 µL inoculum from the culture grown to O.D.600 of 0.8–1.0 was added to 190 µL of LB broth pre-supplemented with colistin sulfate. The pH experiments were carried out in both MHB2 and LB broth. The pH of the broths were adjusted using 1 M HCl or NaOH. MIC experiments were repeated three times. To compare the MICs at identical growth conditions for other experiments description of MICLB is preferred across the manuscript.
Whole-genome sequencing, genome-based taxonomy, and comparative genomic analysis
For whole-genome sequencing, bacterial DNA was isolated from overnight cultures using the PureLink Genomic DNA isolation kit (Thermo Fisher Scientific, Germany) and libraries were prepared using the Nextera XT kit (Illumina), individually tagged libraries and sequenced (2 × 300 bp/2 × 150 bp) on the MiSeq/NextSeq platform (Illumina)50. For ten isolates harboring the mcr-9 gene, long-read sequences were obtained. The library was prepared using the native barcoding kit (EXP-NBD103, Oxford Nanopore Technologies) and 1D chemistry (SQK-LSK108, Oxford Nanopore Technologies). Sequencing was performed on a MinION sequencer (Oxford Nanopore Technologies) using a SpotON Mk I R9 Version flow Cell (FLO‐MIN106, Oxford Nanopore Technologies). Genome sequences are deposited in the public database under the BioProject accession number PRJNA622426.
For bioinformatic analysis, default parameters were used for all software unless otherwise specified. Illumina raw reads were filtered using Trimmomatic v0.36. ONT long reads demultiplexing and adapter trimming were performed using Porechop v0.2.4 (https://github.com/rrwick/Porechop). The reads were examined by FastQC (https://www.bioinformatics.babraham.ac.uk/projects/fastqc/). Only Illumina or Hybrid (Illumina short and ONT long-reads) de novo genome assemblies were performed using Unicycler v0.4.851 (details of the QC stats are provided in Supplementary Data 1c, d)50. Enterobacter species were identified based on the “overall genome related index” (OGRI)52 and included 23 Enterobacter species valid as of June 202253,54. The OGRI was determined by calculating the average nucleotide identity (ANI) and in silico DNA-DNA hybridization score. The ANI was calculated by BLAST using JSpecies v1.2.1 tool55. As the pairwise comparison by JSpecies may differ slightly and is problematic for borderline species56, we also obtained ANI using the two-way approach from the Enveomics package (http://enve-omics.ce.gatech.edu/enveomics/) (with identical settings of JSpecies v1.2.1 alignment program: blast, window size 1020 bp, step size 150 bp, minimum alignment length 714 bp (70%), minimum alignment identity 306 bp (30%)). The in silico DNA-DNA hybridization score was calculated by genome-to-genome distance calculator (GGDC) using formula-2, respectively57.
Phylogenomic grouping was carried out using RhierBAPS58. The lineages were defined based on the concordance of bootstrap supported phylogenomic grouping and BAPS clusters (assignment probability >0.99). Lineage-specific genes were identified by Scoary v1.6.1659. The hsp60 typing was carried out based on the grouping of partial hsp60 gene sequence to that of Hoffmann’s hsp60 gene sequence31. Phylogenomic analysis for worldwide isolates was performed using MASH v2.1.160. Phylogenomic trees and associated meta-data were visualized in iTOL v461. Genetic structures were visualized in Easyfig v2.162. Plasmid incompatibility groups was performed using PlasmidFinder v2.0.163. Single nucleotide variants (SNVs) were identified by mapping filtered reads against the completely closed ESBL3012 genome (generated in this study) using snippy v4.3.6 (https://github.com/tseemann/snippy). Pairwise genomic comparison and visualization were carried out in Ugene v1.32.0 and the “gene presence/absence” output of Roary, and pan-genome-wide association studies were carried out with Scoary.
Antibiotic resistance gene profiling was carried out using NCBI’s AMRfinder (https://www.ncbi.nlm.nih.gov/pathogens/antimicrobial-resistance/AMRFinder/) as well as by “Resistance Gene Identifier” v5.05.5 against CARD database (v3.0.3)64. For mobile colistin resistance gene (mcr), data on clinical and environmental isolates was compiled from NCBI’s Pathogen Detection pipeline (https://www.ncbi.nlm.nih.gov/pathogens/isolates#/search/).
Comparative analysis of genome sequences of Enterobacter spp. obtained worldwide
For comparative genome-based analyses, whole-genome sequences of 3246 non-repetitive isolates (<1000 contigs and >3 Mb assembly size) listed under the genus Enterobacter were downloaded from NCBI using e-utilities v2.0 (Supplementary Data 2). These isolates were obtained from clinical, non-clinical, and unknown sources from more than 67 countries. These isolates were selected after reconfirming them as bona fide Enterobacter species using OGRI tool (as detailed in Supplementary methods).
Population analysis profiling (PAP) test
Isolates were grown as described for MICLB. Serial dilutions of culture with O.D.600 0.8–1.0 were prepared and 100 µL culture (from 10−4, 10−6, and 10−8 dilutions) was plated on LB agar plates containing either 0, 8, or 32 mg/L colistin20. The plates were incubated at 37 °C for 24 h. CFUs were counted using an automatic colony counter (Scan 500, Interscience) and heteroresistance frequency was calculated by estimating “CFUs recovered on plate containing colistin” × 100/“CFUs on plate without colistin.”
Mutant generation and complementation
The mutants for arnBCADTEF, pmrAB, phoPQ, and mgrB genes were generated by homologous recombination using the λ-Red recombination system65. The vector pSIM5-tet carrying the λ-Red genes (γ, β, and exo) was introduced into the strain RBK-17-0394-166. Next, a PCR product for kanamycin resistance gene flanked by FRT-sites (FLP recognition target) was generated from vector pKD4. The transformants carrying the λ-Red recombination system (pSIM5-tet) were grown in LB media containing tetracycline at 30 °C to O.D.600 of 0.4. Thermal induction of λ-Red recombination system was carried out by incubating transformant at 42 °C for 15 min. After thermal induction, the transformants were made electrocompetent by washing cells (3 times) with ice-cold 10% glycerol. After electroporation of the linear PCR product, the mutants were selected on agar plates containing 50 mg/L kanamycin at 30 °C. The vector pSIM5-tet was eliminated by growing cells at 42 °C. All the primers (procured from Eurofins genomics) and vectors used are listed in Supplementary Data 3. For complementation, respective genes with their original promoter region (−60 to −100 bp) were PCR-amplified and cloned in a low-copy broad host range vector pBBR1-MCS2. Recombinant plasmids were transformed in the respective mutants. Hybrid phoP/phoQ mutants were generated by “Gibson Assembly Cloning Kit” (NEB, #E5510S) following the manufacturer’s instructions.
Lipid A extractions
Lipid A was isolated from freshly harvested bacterial cells using ammonium hydroxide-isobutyric acid extraction67. The cells were grown as described for MICLB testing. At an O.D.600 of between 0.8 and 1.0, 5 mL culture were pelleted and resuspended in 400 µL of 70% isobutyric acid and 1 M ammonium hydroxide (5:3, [v/v]) followed by an incubation for 2 h at 100 °C in a screw-cap test tube. The mixture was cooled on ice and centrifuged at 2000 × g for 15 min at 4 °C. The resulting supernatant was diluted with water (1:1, [v/v]) and lyophilized (Thermovac TM201; Leybold-Heraeus, Germany). The sample was washed with 1 mL of methanol and centrifuged at 2000 × g for 15 min at 4 °C. The insoluble lipid A fraction was solubilized and extracted using 100 µL of a mixture of chloroform:methanol:water (3:1.5:0.25, [v/v/v]) and dried prior to further analysis.
Mass spectrometry
All mass spectrometric analyses were performed on a Q Exactive Plus (ThermoFisher Scientific, Germany) using a Triversa Nanomate (Advion, USA) as nano-ESI source. Lipid A extracts were initially dissolved in 20 µL chloroform:methanol:water (60:30:5, [v/v/v]) or chloroform:methanol (8:2, [v/v]). 5 µL of such a solution were mixed with 95 µL of water/propan-2-ol/7 M triethylamine/acetic acid (50:50:0.06:0.02, [v/v/v/v]). In those cases where resulting solutions were too viscous for spraying, 1:10 dilutions in water/propan-2-ol/7 M triethylamine/acetic acid (50:50:0.06:0.02, [v/v/v/v]) were used for the measurement. Mass spectra were recorded for 0.50 min in the negative mode in an m/z-range of 400-2500 applying a spray voltage set of −1.1 kV. All depicted mass spectra were charge deconvoluted (Xtract module of Xcalibur 3.1 software (ThermoFisher Scientific, Germany)), and given mass values refer to the monoisotopic masses of the neutral molecules, if not indicated otherwise. For the calculation of the ratios of non-modified and L-Ara4N-modified lipid A species mass spectrometric data of 143 acquisitions including 6 blanks were imported into one database using LipidXplorer 1.2.868. Monoisotopic peaks of 57 lipid A species were calculated and assigned. Intensities of all observed tetra- to hepta-acylated lipid A species were considered and utilized to determine substitution ratios. Details on the lipid A molecular species, detected ions, and calculation of lipid A species relative abundance can be found in Supplementary Data 4.
Fluorescence microscopy
Bacteria were grown in conditions as used for the MICLB test. From freshly grown cultures (O.D.600 0.8–1.0), 2 mL culture was pelleted (8000 × g for 10 min) and resuspended in 0.85% NaCl. The O.D.600 was adjusted to 0.1 (~108 CFUs/mL) and two sets (1 mL each) were created as treatment and control. For treatment, colistin sulfate was added to the final concentration of 64 mg/L and incubated at room temperature for 15 min. Cells were pelleted, washed twice, and resuspended in 0.85% NaCl solution. To determine cells with intact or compromised cell membranes, we used LIVE/DEAD™ BacLight™ Bacterial Viability Kit (ThermoFisher, # L7012). Equal volumes of component A (SYTO 9, 3.34 mM) and component B (Propidium iodide, 20 mM) were mixed, and 3 µL of dye mixture was added to 1 mL of cell suspension and incubated for 15 min in dark. Cell membrane integrity was also evaluated using FM4-64 (AAT Bioquest, #21487) (that stain membranes red) combined with DAPI (that following entry stains DNA blue). FM4-64 and DAPI were added to the final concentration of 2 and 1 mg/L, respectively, and incubated for 15 min. Labeled bacterial suspensions (5 µL) were visualized under the fluorescence microscope using Plan Apochromat 60X Oil immersion lens (Keyence Biozero BZ-8000K). Images were merged by BZ analyzer v3.61 with default settings for colors (Keyence). For LIVE/DEAD™ staining, cells with green fluorescence were considered cells with intact membrane, while those with red fluorescence were considered membrane-compromised cells. The live/dead count was carried out using ImageJ v1.53e.
RNA extraction, cDNA synthesis, and quantitative PCR
Bacteria were grown as described for the MICLB test. Once the O.D.600 of cultures reached to 0.8–1.0, 1 mL of culture was mixed with RNAprotect reagent and stored at −80 °C. For RNA isolation, the mixture was defrosted on ice and pelleted by centrifugation (8000 × g, 5 min at 4 °C). The pellet was processed by RNeasy Mini Kit (Qiagen, #74124) following the manufacturer’s protocol. The cDNA synthesis was performed using SuperScript II (Invitrogen) using 100 ng of total RNA with random hexamer and nonamer primers. Quantitative PCR amplification was performed by using 1 µL aliquot of a 1st strand cDNA reaction with brilliant SYBR Green qPCR master mix (Qiagen) on the OnePlus real-time cycler (Applied Biosystem) in a final volume of 25 µL. The specificity of all the amplicons was confirmed by gel analysis and melting curves. Experiments were performed in triplicate for three biological replicates. 16S rRNA was used as an endogenous control. Relative quantification was performed using the 2(−ΔΔCt) method69. The primers used are listed in Supplementary Data 3.
Computational modeling of PhoQ and MgrB
To compute interactions between PhoQ sensor protein of E. xiangfangensis RBK-17-0394-1 (WT), E. roggenkampii RPB-17-0516-2 (516), and E. bugandensis RBG-17-0246-1 (246) with MgrB, we used reiterative homology modeling and molecular docking techniques. Homology-based PhoQ models were built using computationally build PhoQ70, as a template structure (https://salilab.org/phoq) through Swiss-model server71. To model the PhoQ periplasmic, trans-membrane and HAMP region 3BQ8.pdb was used for periplasmic domain, 1H2S.pdb was employed for trans-membrane domain, and 2ASW.pdb for HAMP region70. The atomic structure of MgrB was modeled using the AlphaFold server72. The stereo-chemical qualities of modeled structures of PhoQ and MgrB were evaluated using Ramachandran Plot through the PROCHECK73. To explore the interaction of C-terminal periplasmic region of MgrB with periplasmic domain (i.e. acidic region) of PhoQ, molecular docking were performed using HADDOCK74. The analysis and visualization of molecular interactions were performed using the PyMOL Molecular Graphics System, Version 2.0 Schrödinger, LL.
Reporting summary
Further information on research design is available in the Nature Portfolio Reporting Summary linked to this article.
Data availability
The genome sequencing data generated in this study have been deposited in the NCBI database under the BioProject accession number PRJNA622426. Experimental data for antibiotic resistance phenotype, minimum inhibitory concentration (MIC) measurements and mass spectrometry are provided in Supplementary Material, Supplementary, or Source data files. Fluorescence microscopy raw images are submitted as a dataset on Zenodo with DOI: 10.5281/zenodo.7405690. All data are available without any restriction. Source data are provided with this paper.
References
Murray, C. J. et al. Global burden of bacterial antimicrobial resistance in 2019: a systematic analysis. Lancet 399, 629–655 (2022).
Kern, W. V. & Rieg, S. Burden of bacterial bloodstream infection—a brief update on epidemiology and significance of multidrug-resistant pathogens. Clin. Microbiol. Infect. 26, 151–157 (2020).
Thaden, J. T. et al. Increased costs associated with bloodstream infections caused by multidrug-resistant gram-negative bacteria are due primarily to patients with hospital-acquired infections. Antimicrob. Agents Chemother. 61, e01709-16 (2017).
Diekema, D. J. et al. The microbiology of bloodstream infection: 20-year trends from the SENTRY antimicrobial surveillance program. Antimicrob. Agents Chemother. 63, e00355-19 (2019).
Diekema, D. J., Pfaller, M. A., Jones, R. N. & Beach, M. Survey of bloodstream infections due to Gram-negative bacilli: frequency of occurrence and antimicrobial susceptibility of isolates collected in the United States, Canada, and Latin America for the SENTRY antimicrobial surveillance program, 1997. Clin. Infect. Dis. 29, 595–607 (1999).
Tacconelli, E. et al. Discovery, research, and development of new antibiotics: the WHO priority list of antibiotic-resistant bacteria and tuberculosis. Lancet Infect. Dis. 18, 318–327 (2018).
Paauw, A. et al. Genomic diversity within the Enterobacter cloacae complex. PLoS ONE 3, e3018 (2008).
Grimont, F. & Grimont, P. A. D. in The Prokaryotes 197–214 (Springer New York, 2006).
Davin-Regli, A., Lavigne, J.-P. & Pagès, J.-M. Enterobacter spp.: update on taxonomy, clinical aspects, and emerging antimicrobial resistance. Clin. Microbiol. Rev. https://doi.org/10.1128/cmr.00002-19 (2019).
Nation, R. L. & Li, J. Colistin in the 21st century. Curr. Opin. Infect. Dis. 22, 535–543 (2009).
Chavda, K. D. et al. Comprehensive genome analysis of carbapenemase-producingEnterobacter spp.: new insights into phylogeny, population structure, and resistance mechanisms. MBio 7, e02093-16 (2016).
Peirano, G. et al. Genomic epidemiology of global carbapenemase-producingEnterobacter spp., 2008–2014. Emerg. Infect. Dis. 24, 1010–1019 (2018).
Andrade, F. F., Daniela Silva, D., Acácio Rodrigues, A. & Pina-Vaz, C. Colistin update on its mechanism of action and resistance, present and future challenges. Microorganisms 8, 1716 (2020).
Hindler, J. A. & Humphries, R. M. Colistin MIC variability by method for contemporary clinical isolates of multidrug-resistant gram-negative bacilli. J. Clin. Microbiol. 51, 1678–1684 (2013).
WHO. Global Antimicrobial Resistance Surveillance System (GLASS) (WHO, 2018).
WHO. Global Antimicrobial Resistance Surveillance System (GLASS): The Detection and Reporting of Colistin Resistance 2nd edn (WHO, 2021).
Mushtaq, S. et al. Inherent colistin resistance in genogroups of the Enterobacter cloacae complex: epidemiological, genetic and biochemical analysis from the BSAC Resistance Surveillance Programme. J. Antimicrob. Chemother. 75, 2452–2461 (2020).
Gales, A. C., Jones, R. N. & Sader, H. S. Global assessment of the antimicrobial activity of polymyxin B against 54 731 clinical isolates of Gram-negative bacilli: report from the SENTRY antimicrobial surveillance programme (2001–2004). Clin. Microbiol. Infect. 12, 315–321 (2006).
Andersson, D. I., Nicoloff, H. & Hjort, K. Mechanisms and clinical relevance of bacterial heteroresistance. Nat. Rev. Microbiol. 17, 479–496 (2019).
Guérin, F. et al. Cluster-dependent colistin hetero-resistance in Enterobacter cloacae complex. J. Antimicrob. Chemother. 71, 3058–3061 (2016).
Band, V. I. & Weiss, D. S. Heteroresistance: a cause of unexplained antibiotic treatment failure? PLoS Pathog. 15, e1007726 (2019).
Kang, K. N. et al. Colistin heteroresistance in Enterobacter cloacae is regulated by PhoPQ-dependent 4-amino-4-deoxy-l-arabinose addition to lipid A. Mol. Microbiol. 111, 1604–1616 (2019).
Olaitan, A. O., Morand, S. & Rolain, J. M. Mechanisms of polymyxin resistance: acquired and intrinsic resistance in bacteria. Front. Microbiol. 5, 1–18 (2014).
Huang, L., Feng, Y. & Zong, Z. Heterogeneous resistance to colistin in Enterobacter cloacae complex due to a new small transmembrane protein. J. Antimicrob. Chemother. 74, 2551–2558 (2019).
Telke, A. A., Olaitan, A. O., Morand, S. & Rolain, J.-M. soxRS induces colistin hetero-resistance in Enterobacter asburiae and Enterobacter cloacae by regulating the acrAB-tolC efflux pump. J. Antimicrob. Chemother. 72, 2715–2721 (2017).
Pantel, L. et al. Exploring cluster-dependent antibacterial activities and resistance pathways of NOSO-502 and colistin against Enterobacter cloacae complex species. Antimicrob. Agents Chemother. 66, e0077622 (2022).
Elbediwi, M. et al. Global burden of colistin-resistant bacteria: mobilized colistin resistance genes study (1980–2018). Microorganisms 7, 461 (2019).
Kieffer, N. et al. mcr-9, an inducible gene encoding an acquired phosphoethanolamine transferase in Escherichia coli, and its origin. Antimicrob. Agents Chemother.https://doi.org/10.1128/AAC.00965-19 (2019).
El-Halfawy, O. M. & Valvano, M. A. Antimicrobial heteroresistance: an emerging field in need of clarity. Clin. Microbiol. Rev. 28, 191–207 (2015).
Lippa, A. M. & Goulian, M. Feedback inhibition in the PhoQ/PhoP signaling system by a membrane peptide. PLoS Genet. 5, e1000788 (2009).
Hoffmann, H. & Roggenkamp, A. Population genetics of the nomenspecies Enterobacter cloacae. Appl. Environ. Microbiol. 69, 5306–5318 (2003).
Morand, P. C. et al. Specific distribution within the Enterobacter cloacae complex of strains isolated from infected orthopedic implants. J. Clin. Microbiol. 47, 2489–2495 (2009).
Moradigaravand, D., Reuter, S., Martin, V., Peacock, S. J. & Parkhill, J. The dissemination of multidrug-resistantEnterobacter cloacae throughout the UK and Ireland. Nat. Microbiol. 1, 16173 (2016).
Akbari, M., Bakhshi, B. & Najar Peerayeh, S. Particular distribution of Enterobacter cloacae strains isolated from urinary tract infection within clonal complexes. Iran. Biomed. J. 20, 49–55 (2016).
Wang, Y. Q. et al. Rapid identification and subtyping of Enterobacter cloacae clinical isolates using peptide mass fingerprinting. Biomed. Environ. Sci. 31, 48–56 (2018).
Zhou, K. et al. Characterization of the population structure, drug resistance mechanisms and plasmids of the community-associatedEnterobacter cloacae complex in China. J. Antimicrob. Chemother. 73, 66–76 (2018).
Lo-Ten-Foe, J. R., De Smet, A. M. G. A., Diederen, B. M. W., Kluytmans, J. A. J. W. & Van Keulen, P. H. J. Comparative evaluation of the VITEK 2, disk diffusion, etest, broth microdilution, and agar dilution susceptibility testing methods for colistin in clinical isolates, including heteroresistant Enterobacter cloacae and Acinetobacter baumannii strains. Antimicrob. Agents Chemother. 51, 3726–3730 (2007).
Band, V. I. et al. Antibiotic failure mediated by a resistant subpopulation in Enterobacter cloacae. Nat. Microbiol.https://doi.org/10.1038/nmicrobiol.2016.53 (2016).
Band, C. I., Satola, V. I. & Smith, S. W. Colistin heteroresistance is largely undetected among carbapenem-resistant Enterobacterales in the United States. mBio 12, e02881-20 (2021).
Wang, R. et al. The global distribution and spread of the mobilized colistin resistance gene mcr-1. Nat. Commun. 9, 1179 (2018).
Aghapour, Z. et al. Molecular mechanisms related to colistin resistance in Enterobacteriaceae. Infect. Drug Resist. 12, 965–975 (2019).
Dewachter, L., Fauvart, M. & Michiels, J. Bacterial heterogeneity and antibiotic survival: understanding and combatting persistence and heteroresistance. Mol. Cell 76, 255–267 (2019).
Takhaveev, V. & Heinemann, M. Metabolic heterogeneity in clonal microbial populations. Curr. Opin. Microbiol. 45, 30–38 (2018).
Henderson, I. R., Owen, P. & Nataro, J. P. Molecular switches ± the ON and OFF of bacterial phase variation. Mol. Microbiol. 33, 919–932 (1999).
Meouche, I. E. L., Siu, Y. & Dunlop, M. J. Stochastic expression of a multiple antibiotic resistance activator confers transient resistance in single cells. Sci. Rep. 6, 19538 (2016).
Prost, L. R. & Miller, S. I. Salmonellae PhoQ Sens.: mechanisms detection phagosome signals. Cell. Microbiol. 10, 576–582 (2008).
Bader, M. W. et al. Recognition of antimicrobial peptides by a bacterial sensor kinase. Cell 122, 461–472 (2005).
CLSI-EUCAST. Recommendations for MIC determination of colistin (polymyxin E) as recommended by the joint CLSI-EUCAST Polymyxin Breakpoints Working Group. http://www.eucast.org/fileadmin/src/media/PDFs/EUCAST_files/General_documents/Recommendations_for_MIC_determination_of_colistin_March_2016.pdf (2016).
European Committee for Antimicrobial Susceptibility Testing (EUCAST) of the European Society of Clinical Microbiology and Infectious Diseases (ESCMID). Determination of minimum inhibitory concentrations (MICs) of antibacterial agents by broth dilution. Clin. Microbiol. Infect. 9, ix–xv (2003).
Falgenhauer, J. et al. Whole-genome sequences of clinical Enterobacter bugandensis isolates from Germany. Microbiol. Resour. Announc. 8, e00465-19 (2019).
Wick, R. R., Judd, L. M., Gorrie, C. L. & Holt, K. E. Unicycler: resolving bacterial genome assemblies from short and long sequencing reads. PLoS Comput. Biol. 13, e1005595 (2017).
Chun, J. et al. Proposed minimal standards for the use of genome data for the taxonomy of prokaryotes. Int. J. Syst. Evol. Microbiol. 68, 461–466 (2018).
Wu, W., Feng, Y. & Zong, Z. Precise species identification for enterobacter: a genome sequence-based study with reporting of two novel species, Enterobacter quasiroggenkampii sp. nov. and Enterobacter quasimori sp. nov. mSystems 5, e00527-20 (2020).
Cho, G. S. et al. Polyphasic study of antibiotic-resistant enterobacteria isolated from fresh produce in Germany and description of Enterobacter vonholyi sp. nov. isolated from marjoram and Enterobacter dykesii sp. nov. isolated from mung bean sprout. Syst. Appl. Microbiol. 44, 126174 (2021).
Richter, M. et al. Shifting the genomic gold standard for the prokaryotic species definition. Proc. Natl Acad. Sci. USA 106, 19126–19131 (2009).
Figueras, M. J., Beaz-Hidalgo, R., Hossain, M. J. & Liles, M. R. Taxonomic affiliation of new genomes should be verified using average nucleotide identity and multilocus phylogenetic analysis. Genome Announc.https://doi.org/10.1128/genomeA.00927-14 (2014).
Meier-Kolthoff, J. P., Auch, A. F., Klenk, H.-P. & Göker, M. Genome sequence-based species delimitation with confidence intervals and improved distance functions. BMC Bioinformatics 14, 60 (2013).
Tonkin-Hill, G., Lees, J. A., Bentley, S. D., Frost, S. D. W. & Corander, J. RhierBAPs: an R implementation of the population clustering algorithm hierbaps [version 1; referees: 2 approved]. Wellcome Open Res. 3, 93 (2018).
Brynildsrud, O., Bohlin, J., Scheffer, L. & Eldholm, V. Rapid scoring of genes in microbial pan-genome-wide association studies with Scoary. Genome Biol. 17, 238 (2016).
Ondov, B. D. et al. Mash: fast genome and metagenome distance estimation using MinHash. Genome Biol. 17, 132 (2016).
Letunic, I. & Bork, P. Interactive Tree Of Life (iTOL) v4: recent updates and new developments. Nucleic Acids Res. 47, W256–W259 (2019).
Sullivan, M. J., Petty, N. K. & Beatson, S. A. Easyfig: a genome comparison visualizer. Bioinformatics 27, 1009–1010 (2011).
Carattoli, A. et al. In silico detection and typing of plasmids using PlasmidFinder and plasmid multilocus sequence typing. Antimicrob. Agents Chemother. 58, 3895–3903 (2014).
Jia, B. et al. CARD 2017: expansion and model-centric curation of the comprehensive antibiotic resistance database. Nucleic Acids Res. 45, D566–D573 (2017).
Datsenko, K. A. & Wanner, B. L. One-step inactivation of chromosomal genes in Escherichia coli K-12 using PCR products. Proc. Natl Acad. Sci. USAhttps://doi.org/10.1073/pnas.120163297 (2000).
Näsvall, J., Knöppel, A. & Andersson, D. I. Duplication-insertion recombineering: a fast and scar-free method for efficient transfer of multiple mutations in bacteria. Nucleic Acids Res.https://doi.org/10.1093/nar/gkw1078 (2017).
El Hamidi, A., Tirsoaga, A., Novikov, A., Hussein, A. & Caroff, M. Microextraction of bacterial lipid A: easy and rapid method for mass spectrometric characterization. J. Lipid Res. 46, 1773–1778 (2005).
Herzog, R. et al. A novel informatics concept for high-throughput shotgun lipidomics based on the molecular fragmentation query language. Genome Biol.https://doi.org/10.1186/gb-2011-12-1-r8 (2011).
Pfaffl, M. W. A new mathematical model for relative quantification in real-time RT–PCR. Nucleic Acids Res. 29, e45 (2001).
Molnar, K. S. et al. Cys-scanning disulfide crosslinking and bayesian modeling probe the transmembrane signaling mechanism of the histidine kinase, PhoQ. Structure 22, 1239–1251 (2014).
Waterhouse, A. et al. SWISS-MODEL: homology modelling of protein structures and complexes. Nucleic Acids Res. 46, W296–W303 (2018).
Senior, A. W. et al. Improved protein structure prediction using potentials from deep learning. Nature 577, 706–710 (2020).
Laskowski, R. A., MacArthur, M. W., Moss, D. S. & Thornton, J. M. PROCHECK: a program to check the stereochemical quality of protein structures. J. Appl. Cryst. 26, 283–291 (1993).
Dominguez, C., Boelens, R. & Bonvin, A. M. J. J. HADDOCK: a protein-protein docking approach based on biochemical or biophysical information. J. Am. Chem. Soc. 125, 1731–1737 (2003).
Acknowledgements
We thank Christina Gerstmann, Rachel Javorova (Erasmus visiting student), and Michelle Wröbel for excellent technical assistance. This study was supported by grants from the Bundesministerium für Bildung und Forschung within the framework of the German Center for Infection Research (DZIF) and the Deep iAMR project to T.C. (8032808811, 8032808817, 8032808818, 8032808820, 031L0209B). Research in the D.S. laboratory was supported by the German Center for Infection Research (TTU TB DZIF-709).
Funding
Open Access funding enabled and organized by Projekt DEAL.
Author information
Authors and Affiliations
Consortia
Contributions
S.P.D. and T.C. conceived research on colistin resistance/heteroresistance. The clinical study was conducted by the R-Net study group. S.P.D. analyzed genomes and performed the experiments together with R.F. and C.G., and N.G. and D.S. designed and performed the mass spectrometry studies. S.P.D. and R.F. created mutants and performed complementation analysis. B.V.K. carried out protein modeling studies and constructed models. J.F. and C.I. collected isolates, AMR, and other meta-data from partner sites. L.F. carried out the plasmid bioinformatic analysis. Members of consortia, A.M., J.R., M. Behnke, M. Buhl, S.E., P.G., H.G., N.K., W.K., A.K., E.K., S.P., A.R., G.H., H.S., E.T., M.V., S.V.W., and J.Z. provided access to isolates and relevant meta-data for research from respective study sites. C.I., N.G., D.S., and T.C. supervised the work and interpreted the results. T.C. and S.D. wrote the manuscript with inputs from N.G., D.S., and all other authors. T.C. acknowledges assistance from the Shushila and Hoima Podo Chakraborty Foundation during the writing of this manuscript.
Corresponding author
Ethics declarations
Competing interests
The authors declare no competing interests.
Peer review
Peer review information
Nature Communications thanks François Guerin, Sandra Reuter, and the other anonymous reviewer(s) for their contribution to the peer review of this work. Peer review reports are available.
Additional information
Publisher’s note Springer Nature remains neutral with regard to jurisdictional claims in published maps and institutional affiliations.
Source data
Rights and permissions
Open Access This article is licensed under a Creative Commons Attribution 4.0 International License, which permits use, sharing, adaptation, distribution and reproduction in any medium or format, as long as you give appropriate credit to the original author(s) and the source, provide a link to the Creative Commons license, and indicate if changes were made. The images or other third party material in this article are included in the article’s Creative Commons license, unless indicated otherwise in a credit line to the material. If material is not included in the article’s Creative Commons license and your intended use is not permitted by statutory regulation or exceeds the permitted use, you will need to obtain permission directly from the copyright holder. To view a copy of this license, visit http://creativecommons.org/licenses/by/4.0/.
About this article
Cite this article
Doijad, S.P., Gisch, N., Frantz, R. et al. Resolving colistin resistance and heteroresistance in Enterobacter species. Nat Commun 14, 140 (2023). https://doi.org/10.1038/s41467-022-35717-0
Received:
Accepted:
Published:
Version of record:
DOI: https://doi.org/10.1038/s41467-022-35717-0
This article is cited by
-
Characterisation of colistin resistance in Gram-negative microbiota of pregnant women and neonates in Nigeria
Nature Communications (2024)